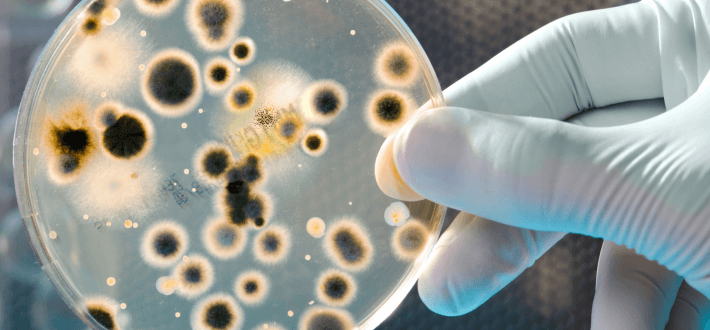
Environmental Factors Affecting Growth

Reef Cora is a vibrant and essential marine coral that supports ocean biodiversity. Found in tropical and subtropical waters, it provides shelter, food, and breeding grounds for numerous marine species.
Its striking colors and diverse forms make it popular in aquariums. Understanding Reef Cora’s care, types, and environmental importance is crucial for hobbyists and conservationists alike.
Reef Cora guide covering types care common problems and solutions. Learn how to maintain healthy corals and support marine ecosystem conservation.
What Makes Reef Cora Special in Marine Ecosystems

Reef Cora, often referred to as coral in aquariums, is a vital marine organism that supports ocean biodiversity. These corals provide shelter, food, and breeding grounds for countless marine species.
Their vibrant colors and unique shapes make them a favorite among aquarists and ocean enthusiasts. Reef Cora is not only aesthetically pleasing but also ecologically significant, maintaining healthy reef ecosystems and supporting marine life across the globe.
Role of Reef Cora in Coral Reefs and Biodiversity
Reef Cora contributes significantly to reef-building processes, forming complex structures that sustain diverse marine populations. Fish, invertebrates, and microorganisms rely on these corals for habitat and survival.
Beyond their ecological role, healthy reefs protect coastlines from erosion and absorb wave energy. Conserving Reef Cora ensures the long-term stability of marine ecosystems and supports global biodiversity.
Different Types of Reef Cora
Hard Reef Cora: Structure and Characteristics
Hard Reef Cora, also called stony coral, forms calcium carbonate skeletons that build the physical foundation of reefs. These corals have rigid structures, providing stability and shelter to marine life.
Examples include brain coral and staghorn coral, known for their intricate shapes and resilience. They thrive in clear, sunlit waters and require stable conditions to grow properly, making them both beautiful and vital for reef integrity.
Soft Reef Cora – Flexibility and Growth Patterns
Soft corals are more flexible than hard corals and often sway with ocean currents. Unlike hard corals, they lack rigid skeletons and rely on water flow for nutrient absorption.
Examples include leather corals and sea fans, which add dynamic movement and texture to reef environments. Soft corals are excellent for aquariums as they are less demanding and adapt well to varying conditions.
Rare and Exotic Reef Cora Species
Certain reef corals are rare or exotic, prized for their unusual colors or growth patterns. Species like flame coral, blue coral, and rainbow coral are highly sought after by collectors.
They require specialized care and optimal conditions, making them challenging but rewarding for aquarists. Preserving rare corals is essential for maintaining genetic diversity and ecological balance in marine habitats.
Physical Features of Reef Cora

Color Variations and Patterns
Reef Cora comes in a wide spectrum of colors, including red, orange, purple, green, and blue. Color depends on coral pigments and the symbiotic algae called zooxanthellae living within their tissues.
Vibrant corals indicate healthy ecosystems, while dull colors may suggest stress or poor water conditions. These color patterns also play a role in attracting fish and other marine organisms.
Growth Shapes, Sizes, and Textures
Corals exhibit various shapes such as branching, boulder-like, plate-like, or encrusting forms. Sizes range from small polyps to massive reef structures spanning meters.
Textures can be smooth, bumpy, or rigid depending on the species. These features influence coral placement in aquariums and determine how they interact with other reef inhabitants.
Identifying Reef Cora in the Wild
Identifying corals involves observing their color, shape, growth pattern, and polyp structure. Divers and marine biologists often use field guides to differentiate species. Accurate identification is crucial for ecological studies, conservation efforts, and selecting suitable corals for aquarium setups.
Natural Habitat and Environment
Ideal Ocean Conditions for Reef Cora
Reef Cora thrives in clear, warm waters with stable salinity and temperature. Sunlight is essential for the photosynthetic algae within corals. Nutrient levels should be balanced, as excess nutrients can lead to algae overgrowth, harming coral health. Healthy water circulation ensures proper gas exchange and nutrient distribution for sustained growth.
Regions Where Reef Cora Naturally Thrives
Corals are found in tropical and subtropical oceans worldwide, particularly in the Indo-Pacific region, the Great Barrier Reef, and the Red Sea. These regions provide optimal sunlight, temperature, and water clarity for coral growth. Coral diversity is highest in these areas, supporting thousands of marine species.
Environmental Factors Affecting Growth
Factors such as temperature fluctuations, pollution, sedimentation, and ocean acidification can impact coral health. Sudden environmental changes may lead to bleaching, disease, or death. Protecting coral habitats from human-induced stressors is vital to maintain reef resilience and biodiversity.
Feeding and Nutritional Needs
How Reef Cora Absorbs Nutrients
Corals are primarily autotrophic, relying on symbiotic algae for nutrients. They also capture plankton and dissolved organic matter from the water using their tentacles. Balanced feeding ensures proper growth, coloration, and reproduction. Both natural reefs and aquariums require careful monitoring of nutrient levels to maintain healthy corals.
Symbiotic Relationships with Marine Life
Reef Cora supports fish, crustaceans, and other invertebrates. Mutualistic relationships include cleaner shrimp living within coral branches and clownfish sheltering in coral crevices. These interactions enhance biodiversity and ecosystem stability, making corals vital for marine life sustainability.
Maintaining Coral Health in Aquariums
In aquariums, corals require stable water parameters, adequate lighting, and proper flow. Regular monitoring, feeding of supplemental nutrients, and occasional pruning ensure vibrant growth. Healthy corals contribute to a balanced ecosystem within aquariums, supporting fish and other invertebrates.
Aquarium Care for Reef Cora
Water Quality, Temperature, and pH Requirements
Optimal coral care involves maintaining stable temperature (24–27°C), pH (8.1–8.4), and salinity (1.023–1.025). Filtration, protein skimmers, and water changes help maintain quality. Poor water conditions can lead to stress, bleaching, or coral death.
Lighting, Flow, and Placement Tips
Reef corals need strong, full-spectrum lighting to support photosynthesis. Placement should ensure moderate to strong water flow, avoiding stagnant areas. Some species prefer shaded areas, while others thrive under direct light. Proper placement enhances growth and coloration.
Common Mistakes to Avoid
Overcrowding, sudden water changes, and overfeeding are common mistakes. Introducing incompatible species can stress corals. Avoid chemical pollutants, unstable temperatures, and inadequate lighting to maintain a thriving reef aquarium.
Common Problems of Reef Cora
problems

- Bleaching: Loss of vibrant color due to stress from high temperatures, poor lighting, or unstable water conditions.
- Pest Infestation: Damage from flatworms, nudibranchs, or small snails.
- Diseases: Bacterial, fungal, or algal infections causing tissue loss or discoloration.
- Polyp Retraction: Polyps retract due to stress, poor water flow, or aggressive tank mates.
- Algae Overgrowth: Excess nutrients lead to algae covering corals, blocking light and slowing growth.
- Physical Damage: Cracks or tissue injuries from handling, strong currents, or aggression from other tank inhabitants.
Solution
- Bleaching Solution: Maintain stable temperature (24–27°C), adjust lighting, and ensure proper water chemistry.
- Pest Infestation Solution: Quarantine new corals, manually remove pests, and use safe coral dips or treatments.
- Disease Solution: Keep water clean, isolate infected corals, and treat with coral-safe medications.
- Polyp Retraction Solution: Ensure proper water flow, correct placement, and reduce overcrowding.
- Algae Overgrowth Solution: Reduce nutrient levels, perform regular water changes, and add algae-eating fish or clean-up crews.
- Physical Damage Solution: Handle corals carefully, provide stable placement, and remove aggressive neighbors.
Ecological and Aesthetic Benefits
Contribution to Marine Biodiversity
Reef Cora supports thousands of marine species by providing shelter, breeding grounds, and feeding areas. Healthy reefs maintain ecological balance and biodiversity, supporting fisheries and human livelihoods.
Enhancing Aquarium Appearance
Vibrant corals enhance aquarium beauty, adding color, structure, and movement. They create a natural habitat, making aquariums visually appealing while supporting fish and invertebrate health.
Importance for Reef Restoration Projects
Corals are central to restoration projects. Propagation, transplantation, and protection of reef corals help recover degraded reefs, strengthen ecosystems, and combat biodiversity loss.
Conservation and Protection Strategies
Threats from Pollution, Climate Change, and Overharvesting
Climate change, ocean acidification, plastic pollution, and unsustainable harvesting threaten corals globally. These factors cause bleaching, disease, and loss of reef structure.
Global Initiatives and Coral Restoration Efforts
Organizations worldwide focus on coral propagation, reef monitoring, and restoration. Marine protected areas, research programs, and sustainable practices help conserve corals for future generations.
How Individuals Can Help Protect Reef Cora
Individuals can reduce plastic use, support sustainable seafood, donate to conservation programs, and raise awareness about coral preservation. Every small action contributes to healthier oceans.
FAQ
1: What is Reef Cora?
Reef Cora is a type of marine coral vital for reef ecosystems, providing habitat, shelter, and nutrients to numerous marine species.
2: How do I care for Reef Cora in an aquarium?
Proper care includes stable temperature, balanced water chemistry, adequate lighting, and regular monitoring to ensure healthy growth and vibrant colors.
3: What are the common problems with Reef Cora?
Common issues include bleaching, pest infestations, diseases, polyp retraction, algae overgrowth, and physical damage caused by handling or poor water conditions.
4: How can I feed Reef Cora?
Reef Cora absorbs nutrients from water and symbiotic algae. Supplemental feeding of plankton or coral foods supports growth in aquariums.
5: How can I protect Reef Cora in the wild?
Protect corals by reducing pollution, supporting sustainable fishing, avoiding coral collection, and promoting marine conservation and reef restoration initiatives.
Conclusion
Reef Cora is not only a stunning marine organism but also a cornerstone of ocean ecosystems. Protecting corals ensures biodiversity, ecosystem stability, and aesthetic value for aquariums and natural reefs. Understanding care, types, and challenges allows enthusiasts and conservationists to support these essential organisms effectively.
Must Read
- Super Bowl 2025 – Predictions, Teams, Highlights & Everything You Need to Know
- Zero Waste Lifestyle – Complete Guide to Sustainable Living for Beginners
- Schedow Review – AI Scheduling Tool to Boost Productivity